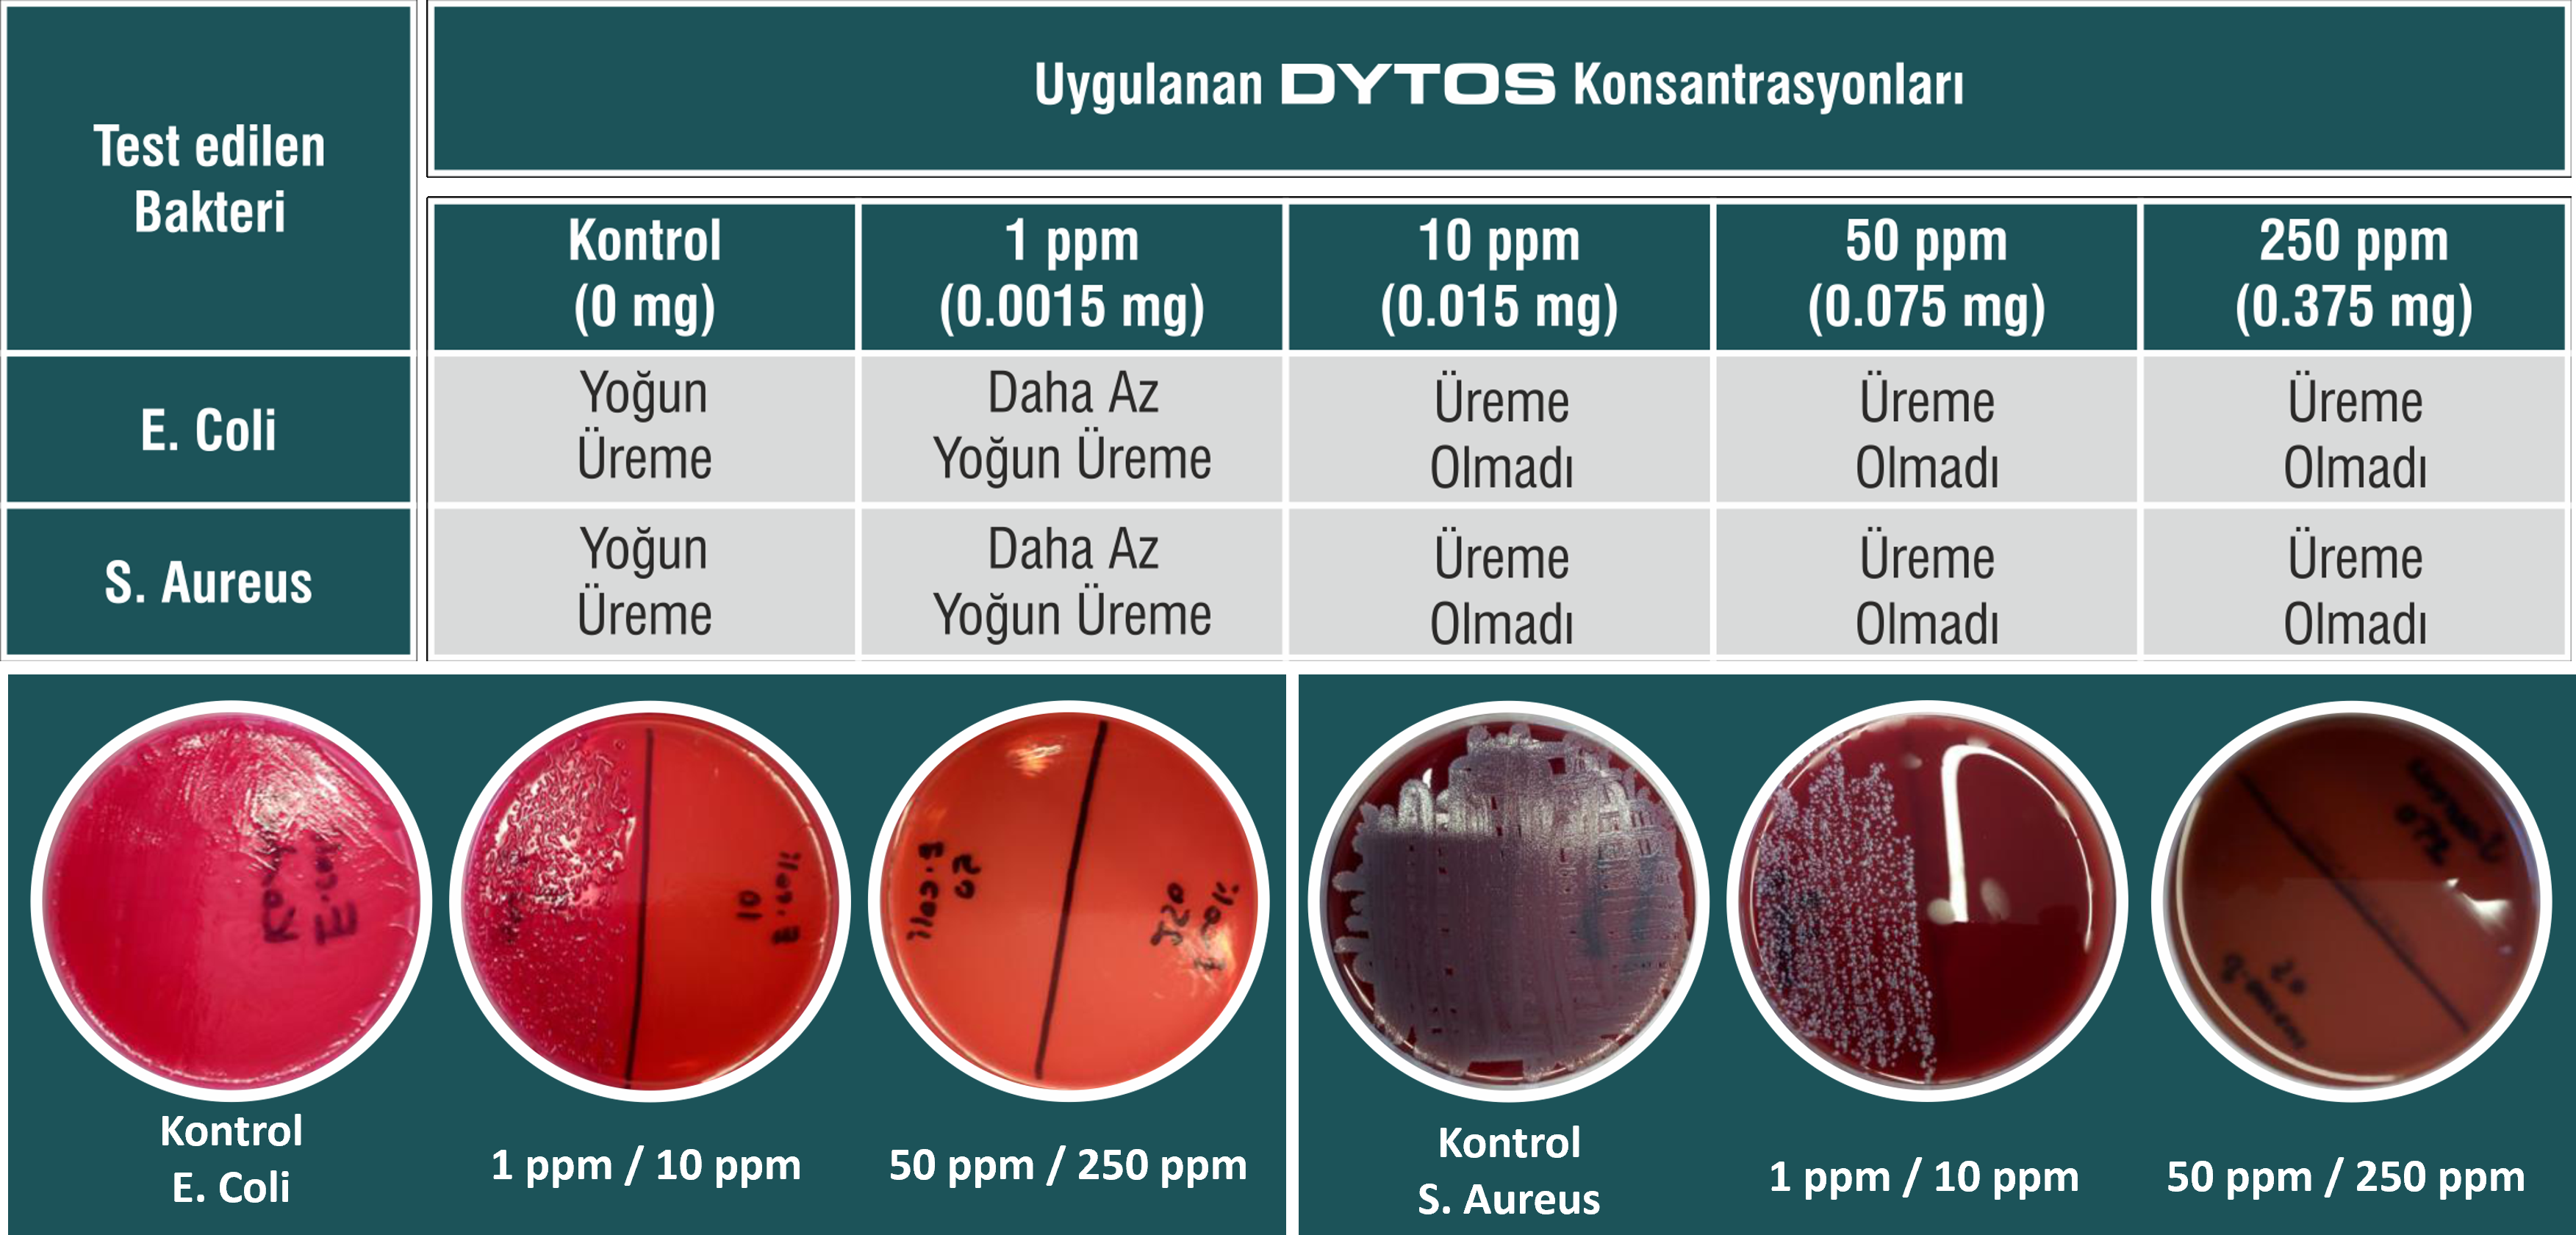

Bu sayfada klor dioksit ve DYTOS hakkındaki genel bilgileri bulabilirsiniz.
Klor dioksit, su içerisinde çözünen keskin klor kokulu bir gazdır. Klor gazı ile karşılaştırıldığında, klor gazı suda hidroliz olurken klor dioksit suda hidroliz olmadan çözünür. Bu durum ona özellikle dezenfeksiyon ajanı olarak kullanılmasında diğer dezenfekte edici ajanlar karşısında büyük bir avantaj sağlar. Su içerisinde çözünmüş gaz olarak kalır. Klor dioksit, klor gazı ve klor bazlı ürünlere göre daha güvenli, etkili ve ucuz olması sebebiyle tüm dünyada tercih edilen dezenfektandır.Klor dioksit’te kimyasal yapısından kaynaklanan bir elektron boşluğu vardır. Bu nedenle kolayca elektron alabilir. Klor dioksit bir patojen yani zararlı mikroorganizma ile karşılaştığında onun hücre duvarından elektron kopartarak alır. Bu sayede zararlı mikroorganizmanın hücre duvarında onarılmayacak bir hasar bırakır. Oluşan hasarlı hücre duvarından hızla içeri giren diğer klor dioksit molekülleri hücre çekirdeğine ulaşır ve aynı bozucu etki ile patojeni öldürür. Klor dioksit virüslerde protein üretimini durdurur ve virüsün ölmesine neden olur.
Klor dioksit güçlü yükseltgendir (oksidan).
Serbest radikal oluşturabildiği için çok hızlı bir şekilde sporları öldürür. Özellikle sporlar gibi mikroorganizmaların inaktif hallerinde de etkilidir.
Yükseltgen özelliğinden dolayı bakteri, virüsler, mantarlar gibi zararlı
mikroorganizmaların amino asit yapısını bozarak onları yok eder.
Mikroorganizmanın hücre duvarını parçalar ve hücre içindeki aminoasitlerle etkileşime
girer. Hücre içindeki yağ asitleriyle de etkileştiği bildirilmiştir.
Virüslerde ise protein üretimini durdurarak yok olmalarını sağlar.
Klor gazının bıraktığı klorinatlı amin, haloasetik asit (HAA), trihalometan (THM) gibi
zararlı kalıntılar bırakmaz. Karsinojen, mutajen etki göstermez (Formaldehit
karsinojendir).
Tat ve koku sorunlarına neden olan fenolleri parçalayarak kötü kokuya son verir.
Bakteri, virüs ve mantar gibi patojen mikroorganizmaların biyofilm tabakası oluşmasını engeller.
Düşük maliyet ile daha fazla dezenfeksiyon sağlar.
Geniş pH aralığında çalışmasından dolayı farklı pH sahip sularda yüksek derecededezenfeksiyon sağlar. Sularda tat ve koku değişikliği yapmaz.
Meyve sebze ve tavukçuluk sektöründe kullanıldığında ürünlerin raf ömürlerini uzatır.
Depodaki suyun yeşillenmesini ve içerisinde mikroorganizma büyümesinden dolayıoluşacak jelleşmeyi önler.
Etkisini uzun süre devam ettirir.
Broiler ve broiler damızlık işletmelerinde ölüm oranını %1-3 oranda azaltır.
Dönem boyunca saha kaynaklı Salmonella riskini önler.
İçme suyunda sürekli kullanım halinde antibiyotik maliyetini düşürür.
Kararlı yapısı nedeniyle jeneratöre gerek olmadan sadece dozaj pompası veya ölçü kabıyladoğrudan kullanılabilmektedir.
Bir kaç dakika gibi kısa süre içinde %99,997 verimle çalışmaktadır.
Klor dioksit bilinen dezenfektanlar ile karşılaştırıldığında metaller üzerinde korozyon yanipaslanma oluşturan oksidasyon gücü düşük bir dezenfektandır.
Klor dioksitin oksidasyon kapasitesi (dezenfeksiyon gücü) diğer oksidanlara göre en az 2.5kat daha güçlü dezenfektandır.
Lambia Giardia ve Cryptosporidium gibi parazitleri ve Rotavirüsler ve E. Coli,
Staphylococcus aureus, Candida alblcans, Pseudomonas aureginosa gibi bakterilere karşıoldukça etkilidir.
Serbest radikal oluşturabildiği için çok hızlı bir şekilde sporları öldürür. Özellikle sporlar gibi mikroorganizmaların inaktif hallerinde de etkilidir.
Yükseltgen özelliğinden dolayı bakteri, virüsler, mantarlar gibi zararlı
mikroorganizmaların amino asit yapısını bozarak onları yok eder.
Mikroorganizmanın hücre duvarını parçalar ve hücre içindeki aminoasitlerle etkileşime
girer. Hücre içindeki yağ asitleriyle de etkileştiği bildirilmiştir.
Virüslerde ise protein üretimini durdurarak yok olmalarını sağlar.
Klor gazının bıraktığı klorinatlı amin, haloasetik asit (HAA), trihalometan (THM) gibi
zararlı kalıntılar bırakmaz. Karsinojen, mutajen etki göstermez (Formaldehit
karsinojendir).
Tat ve koku sorunlarına neden olan fenolleri parçalayarak kötü kokuya son verir.
Bakteri, virüs ve mantar gibi patojen mikroorganizmaların biyofilm tabakası oluşmasını engeller.
Düşük maliyet ile daha fazla dezenfeksiyon sağlar.
Geniş pH aralığında çalışmasından dolayı farklı pH sahip sularda yüksek derecededezenfeksiyon sağlar. Sularda tat ve koku değişikliği yapmaz.
Meyve sebze ve tavukçuluk sektöründe kullanıldığında ürünlerin raf ömürlerini uzatır.
Depodaki suyun yeşillenmesini ve içerisinde mikroorganizma büyümesinden dolayıoluşacak jelleşmeyi önler.
Etkisini uzun süre devam ettirir.
Broiler ve broiler damızlık işletmelerinde ölüm oranını %1-3 oranda azaltır.
Dönem boyunca saha kaynaklı Salmonella riskini önler.
İçme suyunda sürekli kullanım halinde antibiyotik maliyetini düşürür.
Kararlı yapısı nedeniyle jeneratöre gerek olmadan sadece dozaj pompası veya ölçü kabıyladoğrudan kullanılabilmektedir.
Bir kaç dakika gibi kısa süre içinde %99,997 verimle çalışmaktadır.
Klor dioksit bilinen dezenfektanlar ile karşılaştırıldığında metaller üzerinde korozyon yanipaslanma oluşturan oksidasyon gücü düşük bir dezenfektandır.
Klor dioksitin oksidasyon kapasitesi (dezenfeksiyon gücü) diğer oksidanlara göre en az 2.5kat daha güçlü dezenfektandır.
Lambia Giardia ve Cryptosporidium gibi parazitleri ve Rotavirüsler ve E. Coli,
Staphylococcus aureus, Candida alblcans, Pseudomonas aureginosa gibi bakterilere karşıoldukça etkilidir.
DYTOS’un etkili olduğu bazı bakteri, virüs ve mantarları aşağıda bulabilirsiniz.
BAKTERİLER: Blakeslea trispora, Bordetella bronchiseptica, Brucella suis, Burkholderia mallei, Burkholderia pseudomallei, Campylobacter jejuni, Clostridium botulinum, Corynebacterium bovis, Coxiella burneti (Q-fever), E. Coli, Erwinia carotovora (soft rot), Franscicella tularensis, Fusarium sambucinum (dry rot), Fusarium solani var. coeruleum (dry rot), Helicobacter pylori, Helminthosporium solani (silver scurf), Klebsiella pneumonia, Lactobacillus acidophilus, Lactobacillus brevis, Lactobacillus buchneri, Lactobacillus plantarum, Legionella, Clostridium dificile, Legionella pneumophila, Leuconostoc citreum, Leuconostoc mesenteroides, Listeria innocua, Listeria monocytogenes, Methicillin-resistant Staphylococcus aureus (MRSA), Multiple Drug Resistant Salmonella typhimurium (MDRS), Mycobacterium bovis, Mycobacterium fortuitum, Pediococcus acidilactici, Pseudomonas aeruginosa, Salmonella, Shigella, Staphylococcus aureus, Staphylococcus faecalis, Tuberculosis, Vancomycin-resistant Enterococcus faecalis (VRE), Vibrio strain, Yersinia enterocolitica, Yersinia pestis, Yersinia ruckerii
VİRÜSLER: Adenovirus Type, Calicivirus, Canine Parvovirus, Coronavirus, Feline Calici Virus, Foot and Mouth disease, Hantavirus, Hepatitis A Virus, Hepatitis B & C Viruses, Human coronavirus, Human Immunodeficiency Virus, Human Rotavirus type 2 (HRV), Influenza A, Minute Virus of Mouse (Parovirus)(MVM-i), Minute Virus of Mouse (Parovirus)(MVM-p), Mouse Hepatitis Virus, Murine Parainfluenza Virus Type 1 (Sendai), Newcastle Disease Virus, Norwalk Virus, Poliovirus, Rotavirus, Severe Acute Respiratory Syndrome (SARS), Sialodscryoadenitis Virus (Coronavirus)(SDAV), Simian rotavirus SA-11, Theiler’s Mouse Encephalomyelitis Virus (TMEV), Vaccinia Virus
MANTAR/ALGLER/KÜF/MAYA: Alternaria alternata, Aspergillus, Botrytis species ,Candida, Chaetomium globosum, Cladosporium cladosporioides, Debaryomyces etchellsii, Eurotium, Fusarium solani, Lodderomyces elongisporus, Mucor, Penicillium, Phormidium boneri, Pichia pastoris, Poitrasia circinans, Rhizopus oryzae, Roridin A, Saccharomyces cerevisiae, Stachybotryschartarum, T-mentag (athlete’s foot fungus), Verrucarin A
BAKTERİLER: Blakeslea trispora, Bordetella bronchiseptica, Brucella suis, Burkholderia mallei, Burkholderia pseudomallei, Campylobacter jejuni, Clostridium botulinum, Corynebacterium bovis, Coxiella burneti (Q-fever), E. Coli, Erwinia carotovora (soft rot), Franscicella tularensis, Fusarium sambucinum (dry rot), Fusarium solani var. coeruleum (dry rot), Helicobacter pylori, Helminthosporium solani (silver scurf), Klebsiella pneumonia, Lactobacillus acidophilus, Lactobacillus brevis, Lactobacillus buchneri, Lactobacillus plantarum, Legionella, Clostridium dificile, Legionella pneumophila, Leuconostoc citreum, Leuconostoc mesenteroides, Listeria innocua, Listeria monocytogenes, Methicillin-resistant Staphylococcus aureus (MRSA), Multiple Drug Resistant Salmonella typhimurium (MDRS), Mycobacterium bovis, Mycobacterium fortuitum, Pediococcus acidilactici, Pseudomonas aeruginosa, Salmonella, Shigella, Staphylococcus aureus, Staphylococcus faecalis, Tuberculosis, Vancomycin-resistant Enterococcus faecalis (VRE), Vibrio strain, Yersinia enterocolitica, Yersinia pestis, Yersinia ruckerii
VİRÜSLER: Adenovirus Type, Calicivirus, Canine Parvovirus, Coronavirus, Feline Calici Virus, Foot and Mouth disease, Hantavirus, Hepatitis A Virus, Hepatitis B & C Viruses, Human coronavirus, Human Immunodeficiency Virus, Human Rotavirus type 2 (HRV), Influenza A, Minute Virus of Mouse (Parovirus)(MVM-i), Minute Virus of Mouse (Parovirus)(MVM-p), Mouse Hepatitis Virus, Murine Parainfluenza Virus Type 1 (Sendai), Newcastle Disease Virus, Norwalk Virus, Poliovirus, Rotavirus, Severe Acute Respiratory Syndrome (SARS), Sialodscryoadenitis Virus (Coronavirus)(SDAV), Simian rotavirus SA-11, Theiler’s Mouse Encephalomyelitis Virus (TMEV), Vaccinia Virus
MANTAR/ALGLER/KÜF/MAYA: Alternaria alternata, Aspergillus, Botrytis species ,Candida, Chaetomium globosum, Cladosporium cladosporioides, Debaryomyces etchellsii, Eurotium, Fusarium solani, Lodderomyces elongisporus, Mucor, Penicillium, Phormidium boneri, Pichia pastoris, Poitrasia circinans, Rhizopus oryzae, Roridin A, Saccharomyces cerevisiae, Stachybotryschartarum, T-mentag (athlete’s foot fungus), Verrucarin A
Staphylococcusaureus ATCC 25923 (S. Aureus) ve Escherichiacoli ATCC 25922 (E. Coli) suşlarının 18 saatlik kültürlerinden McFarland No:1’e göre FTS içinde hazırlanansüspansiyonları (yaklaşık 300×106 bakteri / 1mL) bir yüzeye yayılarak farklı konsantrasyonlarındaki (1, 10, 50 ve 250 ppm) 1.5 g DYTOS ile muamele edildi, 15 dakika beklendikten sonra svap ile MacConkeyagar ve Kanlı agarbesiyerlerine ekimler yapıldı. Kontrol olarak DYTOS ile muamele edilmeden doğrudan bakteri yayılan yüzeyden ekim yapıldı. Kontrol ekiminde yoğun üreme gözlemlenirken, 1 ppm muamele edilen yüzeyde az yoğun üreme gözlemlendi. 10 ppm, 50 ppm ve 250 ppm ile muamele edilen yüzeylerde ise hiç üreme olmadı. Özetle DYTOS çok düşük konsantrasyonlarda bile yüksek etkiye sahip bir dezenfektandır.

Tip 2 (Yer-Yüzey dezenfeksiyonu Umumi ve kişisel Silme spreyleme sisleme) için 150 ppm kullanımı yeterlidir. 150 ppm konsantrasyonuna ulaşmak için %5 DYTOS kullanımı gereklidir. Yani 100 litre suya yalnızca 5 litre DYTOS ekleyerek, 150 ppm çözelti elde edersiniz?
Tip 3 (Veteriner hijyenine yönelik Sisleme-spreyleme) için 100 ppm kullanımı yeterlidir. 100 ppm konsantrasyonuna ulaşmak için %3,5 DYTOS kullanımı gereklidir. Yani 100 litre suya yalnızca 3,5 litre DYTOS ekleyerek, 150 ppm çözelti elde edersiniz?
Tip 5 (İçme suyu dezenfeksiyonu) için 0,4 ppm kullanımı yeterlidir. 0,4 ppm konsantrasyonuna ulaşmak için %0,013 DYTOS kullanımı gereklidir. Yani 100 litre suya yalnızca 13 mililitre DYTOS ekleyerek, 0,4 ppm çözelti elde edersiniz?

Tip 3 (Veteriner hijyenine yönelik Sisleme-spreyleme) için 100 ppm kullanımı yeterlidir. 100 ppm konsantrasyonuna ulaşmak için %3,5 DYTOS kullanımı gereklidir. Yani 100 litre suya yalnızca 3,5 litre DYTOS ekleyerek, 150 ppm çözelti elde edersiniz?
Tip 5 (İçme suyu dezenfeksiyonu) için 0,4 ppm kullanımı yeterlidir. 0,4 ppm konsantrasyonuna ulaşmak için %0,013 DYTOS kullanımı gereklidir. Yani 100 litre suya yalnızca 13 mililitre DYTOS ekleyerek, 0,4 ppm çözelti elde edersiniz?

DYTOS 0,25 LT, 1 LT, 5 LT ve 20 LT olarak üretilip, satışa sunulmaktadır. Ayrıca ihtiyaca özel olarak 1 tonluk IBC tanklarla da üretimi ve teslimatı yapılabilmektedir.
Firmamız gerekli olan tüm belgeler için gerekli çalışmaları ve başvuruları yaparak, aşağıdaki belgeleri almıştır.
ISO 9001 – 2015 Kalite Yönetim Sistemi Belgesi, ISO 14001 – 2015 Çevre Yönetim Sistemi Belgesi, DYTOS Marka Tescil Belgesi ve Sağlık Bakanlığı Biyosidal Ürün Ruhsatı belgesi mevcuttur.

ISO 9001 – 2015 Kalite Yönetim Sistemi Belgesi, ISO 14001 – 2015 Çevre Yönetim Sistemi Belgesi, DYTOS Marka Tescil Belgesi ve Sağlık Bakanlığı Biyosidal Ürün Ruhsatı belgesi mevcuttur.

Klor Dioksit aktif maddeleri ürünler biyosidal ürün olarak tanımlanmakta ve ruhsata tabi tutulmaktadır. İlgili ruhsat sağlık bakanlığı tarafından sıkı denetim ve testler sonrasında verilmektedir. Ruhsatsız ürünler merdiven altı diye tabir edilen firmalarca nasıl üretildiği belli olmadan genellikle “PH Düzenleyici” maskelemesiyle piyasaya sürülmekte ve kullanıma sunulmaktadır. Denetlenmeyen firma ve ürünler, halk sağlığı için ciddi tehditler oluşturmaktadır. Ayrıca ruhsatsız biyosidal ürün üretmek veya satmanın ciddi yaptırımları bulunmaktadır. Sağlığınız ve güvenliğiniz için, lütfen ruhsatlı ürünleri tercih edin. Ayrıca ruhsatsız ürünlerin ihbarı, herkes için vatandaşlık görevidir.
Sağlık Bakanlığınca ruhsat sürecinde yapılan testler sonucunda belirlenen raf ömrümüz ambalaj açılmadığı ve ambalaj üzerinde yazan saklama koşullarına uyulduğu sürece 120 gündür. Eğer ambalajı açtıysanız, raf ömrümüz 60 gündür.
DYTOS orijinal ambalajında, kuru ve serin (25 0C ±2), direkt oplarak güneş ışığı almayan yerlerde muhafaza ediniz. Alanın iyi havalandırılmış olmasına dikkat ediniz. Olası sızıntıları önlemek için, ambalajları dik konumda muhafaza ediniz. Ayrıca asitler, alkaliler ve oksidan maddelerden uzakta tutunuz.
Ruhsata tabi herhangi bir ürünün ruhsatının olması halinde, ürün ambalajından ruhsat numarası ve tarihini görebilirsiniz ancak ruhsat çeşitli sebeplerle iptal olmuş olabilir. Buraya tıklayarak, açılan sayfada üretici firma ismini, ürün ismini veya ruhsat numarasını girerek, sorgulama yapabilirsiniz.
